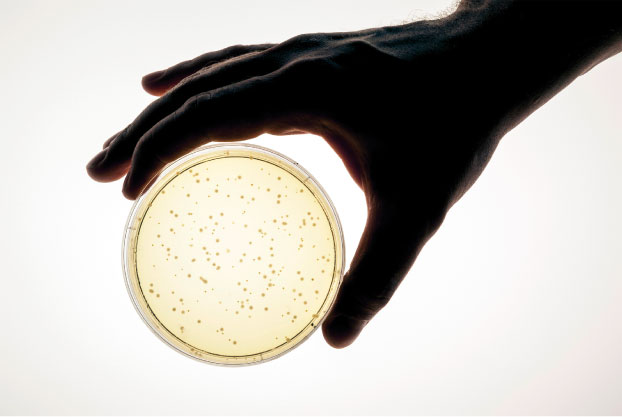

Servicios

Desarrollo de estudios y soluciones innovadoras personalizadas según las necesidades de tu empresa.
Análisis de procesos para generar mayor efciencia operativa y un impacto positivo en la cadena de valores.
Una herramienta que permite tomar decisiones informadas para buscar la sostenibilidad.
Medición de impacto y ajuste de estrategias.
Te armamos un presupuesto según tus necesidades.
Nuestro equipo está integrado por científicos especializados en medio ambiente, ciencias de la tierra, impacto ambiental de los plásticos y expertos en branding, que traducen la investigación en mensajes claros y efectivos, y profesionales de marketing que aseguran que la información llegue a los públicos adecuados.
Juntos, trabajamos para asesorar a empresas en la toma de decisiones basadas en datos, creando estrategias que no solo reduzcan el impacto ambiental, sino que también generen un cambio real y sostenible.



